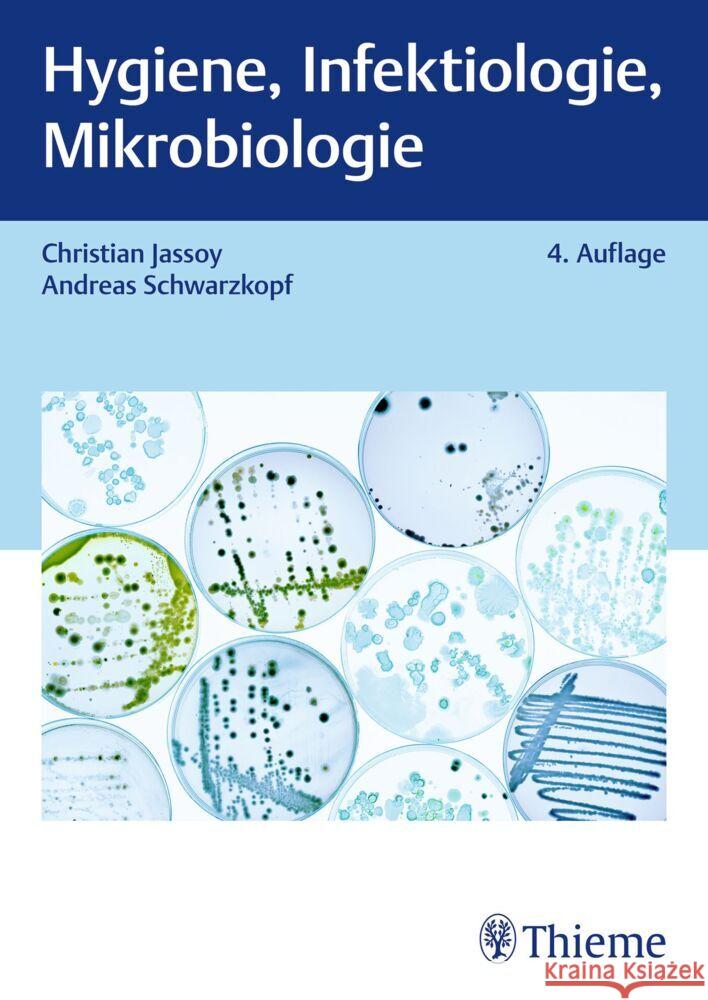
Hygiene, Infektiologie, Mikrobiologie Schwarzkopf, Andreas, Jassoy, Christian 9783132447233 Thieme, Stuttgart - książka

Hygiene, Infektiologie, Mikrobiologie » książka
Hygiene, Infektiologie, Mikrobiologie
ISBN-13: 9783132447233 / Niemiecki / Miękka / 436 str.
Infektionskrankheiten verstehen, vermeiden, bekämpfen
Alles was du im Bereich Hygiene, Infektiologie und Mikrobiologie wissen musst. Eigne dir exakt auf die Pflege bzw. Gesundheitsberufe zugeschnittenes Detailwissen an - spare dir unnötigen, fachmedizinischen Wissensballast.
Zahlreiche Praxistipps zeigen dir, worauf es bei der Bekämpfung pathogener Mikroorganismen wirklich ankommt. Generalistische Wegweiser ermöglichen ein schnelles Auffinden der wichtigsten Inhalte für die Gesundheits- und Kinderkrankenpflege und die Altenpflege. Erfahre alles Wesentliche zu neuen Erregern und Krankheitsüberträgern. Lerne Labormethoden, Isolationsmaßnahmen sowie Standards bei Händehygiene und Handschuhmanagement kennen. 5 Fallbeispiele mit Lösungen unterstützen dich bei der Selbstkontrolle und Prüfungsvorbereitung.
Die 4. Auflage wurde komplett aktualisiert und um folgende Inhalte erweitert:
- Infektionsepidemiologie
- Corona-Pandemie/SARS CoV-2-Infektion
- Affenpocken
Dein nützlicher Begleiter zum Thema Hygiene für deine Ausbildung oder als Hygienefachkraft. Fühle dich sicher. Schütze dich und die von dir gepflegten bzw. betreuten Personen beim alltäglichen Arbeiten.